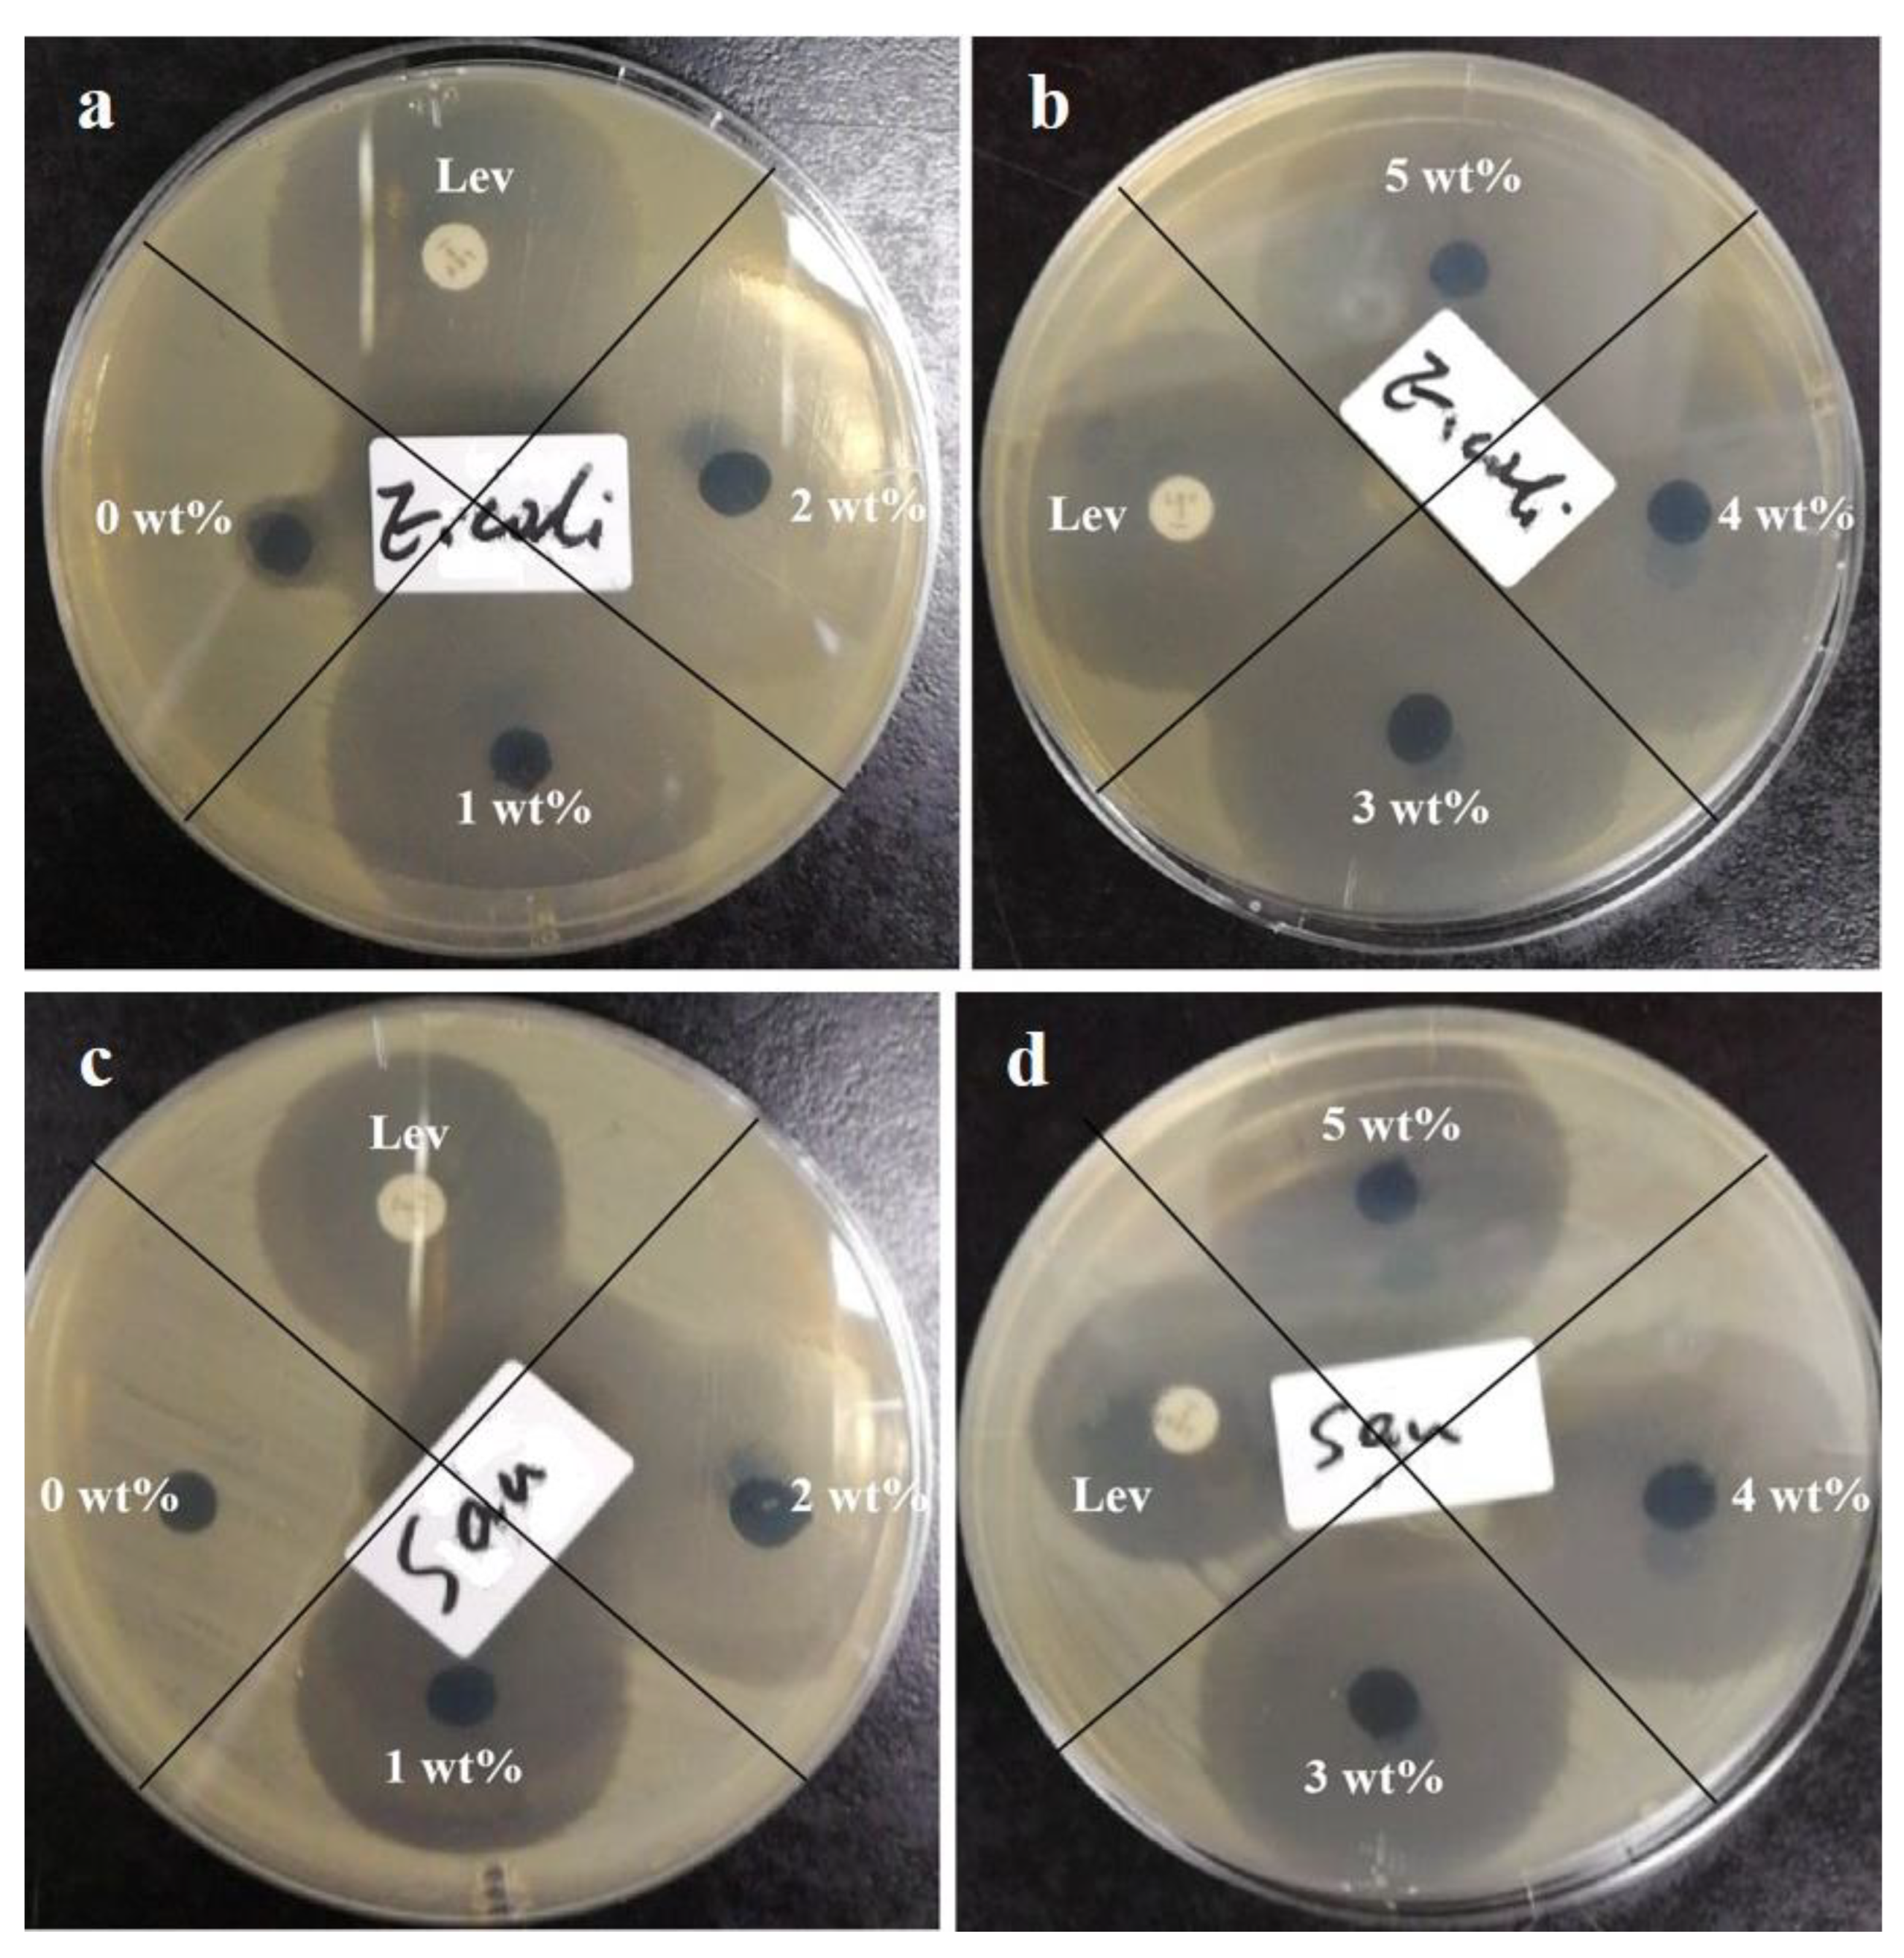

Preparation of Antibacterial Gelatin/Genipin Nanofibrous Membrane for Tympanic Membrane Repair
Abstract
:1. Introduction
2. Materials and Methods
2.1. Materials
2.2. Electrospinning Precursor
2.3. Nanofibrous Membranes via Electrospinning
2.4. Crosslinking of Nanofibrous Membranes
2.5. Characterization
2.5.1. Surface Tension Characterization
2.5.2. Morphological Characterization
2.5.3. Fourier Transform Infrared Spectroscopy
2.5.4. Water Contact-Angle Measurement
2.5.5. Mechanical Properties Test
2.5.6. Thermostability Analysis
2.5.7. Cytotoxicity Assay
2.5.8. Antibacterial Assay
3. Results and Discussion
3.1. Pre-Characterization
3.2. Morphology of Gelatin/Genipin/Levofloxacin Nanofibers
3.3. Fourier Transform Infrared Spectroscopy
3.4. Water Contact Angles
3.5. Mechanical Properties
3.6. Cell Viability and Proliferation
3.7. Antibacterial Properties
4. Conclusions
Supplementary Materials
Author Contributions
Funding
Institutional Review Board Statement
Informed Consent Statement
Data Availability Statement
Conflicts of Interest
Sample Availability
References
- Cleeton, C.; Keirouz, A.; Chen, X.; Radacsi, N. Electrospun Nanofibers for Drug Delivery and Biosensing. ACS Biomater. Sci. Eng. 2019, 5, 4183–4205. [Google Scholar] [CrossRef] [PubMed]
- Sharma, D.; Saha, S.; Satapathy, B.K. Recent advances in polymer scaffolds for biomedical applications. J. Biomater. Sci. Polym. Ed. 2022, 33, 342–408. [Google Scholar] [CrossRef] [PubMed]
- Ribeiro, N.; Sousa, A.; Cunha-Reis, C.; Oliveira, A.L.; Granja, P.L.; Monteiro, F.J.; Sousa, S.R. New prospects in skin regeneration and repair using nanophased hydroxyapatite embedded in collagen nanofibers. Nanomed. Nanotechnol. Biol. Med. 2021, 33, 102353. [Google Scholar] [CrossRef] [PubMed]
- Kim, S.W.; Kim, J.; Seonwoo, H.; Jang, K.J.; Kim, Y.J.; Lim, H.J.; Lim, K.T.; Tian, C.; Chung, J.H.; Choung, Y.H. Latent progenitor cells as potential regulators for tympanic membrane regeneration. Sci. Rep. 2015, 5, 11542. [Google Scholar] [CrossRef]
- Carr, S.D.; Strachan, D.R.; Raine, C.H. Factors affecting myringoplasty success. J. Laryngol. Otol. 2015, 129, 23–26. [Google Scholar] [CrossRef] [Green Version]
- Isaacson, G.; Harounian, J.A. Results of pediatric endoscopic and endoscopically assisted tympanoplasty. World J. Otorhinolaryngol. Head Neck Surg. 2017, 3, 136–141. [Google Scholar] [CrossRef]
- Liu, X.; Xu, H.; Zhang, M.; Yu, D.G. Electrospun Medicated Nanofibers for Wound Healing: Review. Membranes 2021, 11, 770. [Google Scholar] [CrossRef]
- Yang, C.; Shao, Q.; Han, Y.; Liu, Q.; He, L.; Sun, Q.; Ruan, S. Fibers by Electrospinning and Their Emerging Applications in Bone Tissue Engineering. Appl. Sci. 2021, 11, 9082. [Google Scholar] [CrossRef]
- Mokhtari, F.; Azimi, B.; Salehi, M.; Hashemikia, S.; Danti, S. Recent advances of polymer-based piezoelectric composites for biomedical applications. J. Mech. Behav. Biomed. Mater. 2021, 122, 104669. [Google Scholar] [CrossRef]
- Rahmati, M.; Mills, D.K.; Urbanska, A.M.; Saeb, M.R.; Venugopal, J.R.; Ramakrishna, S.; Mozafari, M. Electrospinning for tissue engineering applications. Prog. Mater. Sci. 2021, 117, 100721. [Google Scholar] [CrossRef]
- Günday, C.; Anand, S.; Gencer, H.B.; Munafò, S.; Moroni, L.; Fusco, A.; Donnarumma, G.; Ricci, C.; Hatir, P.C.; Türeli, N.G.; et al. Ciprofloxacin-loaded polymeric nanoparticles incorporated electrospun fibers for drug delivery in tissue engineering applications. Drug Deliv. Transl. Res. 2020, 10, 706–720. [Google Scholar] [CrossRef] [PubMed]
- Jang, C.H.; Cho, Y.B.; Yeo, M.; Lee, H.; Min, E.J.; Lee, B.H.; Kim, G.H. Regeneration of chronic tympanic membrane perforation using 3D collagen with topical umbilical cord serum. Int. J. Biol. Macromol. 2013, 62, 232–240. [Google Scholar] [CrossRef] [PubMed]
- Huang, M.; Li, J.; Chen, J.; Zhou, M.; He, J. Preparation of CS/PVA Nanofibrous Membrane with Tunable Mechanical Properties for Tympanic Member Repair. Macromol. Res. 2018, 26, 892–899. [Google Scholar] [CrossRef]
- Li, L.; Zhang, W.; Huang, M.; Li, J.; Chen, J.; Zhou, M.; He, J. Preparation of gelatin/genipin nanofibrous membrane for tympanic member repair. J. Biomater. Sci. Polym. Ed. 2018, 29, 2154–2167. [Google Scholar] [CrossRef]
- Wang, B.; Xin, T.; Shen, L.; Zhang, K.; Zhang, D.; Zhang, H.; Liu, J.; Chen, B.; Cui, W.; Shu, Y. Acoustic transmitted electrospun fibrous membranes for tympanic membrane regeneration. Chem. Eng. J. 2021, 419, 129536. [Google Scholar] [CrossRef]
- Omae, K.; Kanemaru, S.I.; Nakatani, E.; Kaneda, H.; Nishimura, T.; Tona, R.; Naito, Y.; Kawamoto, A.; Fukushima, M. Regenerative treatment for tympanic membrane perforation using gelatin sponge with basic fibroblast growth factor. Auris Nasus Larynx 2017, 44, 664–671. [Google Scholar] [CrossRef]
- Sun, W.; Gregory, D.A.; Tomeh, M.A.; Zhao, X. Silk Fibroin as a Functional Biomaterial for Tissue Engineering. Int. J. Mol. Sci. 2021, 22, 1499. [Google Scholar] [CrossRef]
- Kozin, E.D.; Black, N.L.; Cheng, J.T.; Cotler, M.J.; McKenna, M.J.; Lee, D.J.; Lewis, J.A.; Rosowski, J.J.; Remenschneider, A.K. Design, fabrication, and in vitro testing of novel three-dimensionally printed tympanic membrane grafts. Hear. Res. 2016, 340, 191–203. [Google Scholar] [CrossRef] [Green Version]
- Ding, Y.; Li, W.; Correia, A.; Yang, Y.; Zheng, K.; Liu, D.; Schubert, D.W.; Boccaccini, A.R.; Santos, H.A.; Roether, J.A. Electrospun Polyhydroxybutyrate/Poly(ε-caprolactone)/Sol-Gel-Derived Silica Hybrid Scaffolds with Drug Releasing Function for Bone Tissue Engineering Applications. ACS Appl. Mater. Interfaces 2018, 10, 14540–14548. [Google Scholar] [CrossRef] [Green Version]
- Ajmal, G.; Bonde, G.V.; Mittal, P.; Khan, G.; Pandey, V.K.; Bakade, B.V.; Mishra, B. Biomimetic PCL-gelatin based nanofibers loaded with ciprofloxacin hydrochloride and quercetin: A potential antibacterial and anti-oxidant dressing material for accelerated healing of a full thickness wound. Int. J. Pharm. 2019, 567, 118480. [Google Scholar] [CrossRef]
- Chen, Z.; Benecke, L.; Kempert, P.; Stoppe, T.; Bornitz, M.; Neudert, M.; Aibibu, D.; Cherif, C.; Zahnert, T. Simulation and Development of Biomimetic Electrospun PCL Nanofibrous Tympanic Membrane Implants. PAMM 2021, 20, e202000100. [Google Scholar] [CrossRef]
- Zhang, X.; Li, L.; Ouyang, J.; Zhang, L.; Xue, J.; Zhang, H.; Tao, W. Electroactive electrospun nanofibers for tissue engineering. Nano Today 2021, 39, 101196. [Google Scholar] [CrossRef]
- Shaw, G.S.; Samavedi, S. Potent Particle-Based Vehicles for Growth Factor Delivery from Electrospun Meshes: Fabrication and Functionalization Strategies for Effective Tissue Regeneration. ACS Biomater. Sci. Eng. 2022, 8, 1–15. [Google Scholar] [CrossRef] [PubMed]
- Ferreira, C.A.M.; Januário, A.P.; Félix, R.; Alves, N.; Lemos, M.F.L.; Dias, J.R. Multifunctional Gelatin/Chitosan Electrospun Wound Dressing Dopped with Undaria pinnatifida Phlorotannin-Enriched Extract for Skin Regeneration. Pharmaceutics 2021, 13, 2152. [Google Scholar] [CrossRef]
- Khan, H.; Shukla, R.N.; Bajpai, A.K. Genipin-modified gelatin nanocarriers as swelling controlled drug delivery system for in vitro release of cytarabine. Mater. Sci. Eng. C 2016, 61, 457–465. [Google Scholar] [CrossRef]
- Beikzadeh, S.; Hosseini, S.M.; Mofid, V.; Ramezani, S.; Ghorbani, M.; Ehsani, A.; Mortazavian, A.M. Electrospun ethyl cellulose/poly caprolactone/gelatin nanofibers: The investigation of mechanical, antioxidant, and antifungal properties for food packaging. Int. J. Biol. Macromol. 2021, 191, 457–464. [Google Scholar] [CrossRef] [PubMed]
- Panzavolta, S.; Gioffrè, M.; Focarete, M.L.; Gualandi, C.; Foroni, L.; Bigi, A. Electrospun gelatin nanofibers: Optimization of genipin cross-linking to preserve fiber morphology after exposure to water. Acta Biomater. 2011, 7, 1702–1709. [Google Scholar] [CrossRef]
- Lu, A.; Ma, Z.; Zhuo, J.; Sun, G.; Zhang, G. Layer-by-layer structured gelatin nanofiber membranes with photoinduced antibacterial functions. J. Appl. Polym. Sci. 2013, 128, 970–975. [Google Scholar] [CrossRef]
- Cai, N.; Li, C.; Han, C.; Luo, X.; Shen, L.; Xue, Y.; Yu, F. Tailoring mechanical and antibacterial properties of chitosan/gelatin nanofiber membranes with Fe3O4 nanoparticles for potential wound dressing application. Appl. Surf. Sci. 2016, 369, 492–500. [Google Scholar] [CrossRef]
- Liu, H.; Zhang, X.; Wang, T.; Huang, X.; Chen, K.; Wang, N.; Yu, S.; Dong, Y.; Hao, H. Thermodynamic and kinetic mechanism of phase transformation of levofloxacin hydrochloride. Particuology 2022, 66, 59–70. [Google Scholar] [CrossRef]
- Wrońska, N.; Majoral, J.P.; Appelhans, D.; Bryszewska, M.; Lisowska, K. Synergistic Effects of Anionic/Cationic Dendrimers and Levofloxacin on Antibacterial Activities. Molecules 2019, 24, 2894. [Google Scholar] [CrossRef] [PubMed] [Green Version]
- Steyaert, I.; Hubert, R.; Jos, O.; Karen De, C.; Sandra Van, V. Gelatin nanofibers: Analysis of triple helix dissociation temperature and cold-water-solubility. Food Hydrocoll. 2016, 57, 200–208. [Google Scholar] [CrossRef]
- Bhardwaj, V.; Bhardwaj, T.; Sharma, K. Thermo-acoustic investigation of sodium dodecyl sulfate and antimicrobial drug (Levofloxacin) for potential pharmaceutical application. RSC Adv. 2014, 4, 47. [Google Scholar] [CrossRef]
- Xiao, J.; Huang, Y.; Yingjie, H.U. Molecular dynamics simulation of mechanical properties of TATB/fluorine-polymer PBXs along different surfaces. Sci. China Ser. B Chem. 2005, 48, 504–510. [Google Scholar] [CrossRef]
- Wang, Y.L.; Hu, Y.; Xu, Z.L. Influence of post-treatments on the properties of porous poly(vinyl alcohol) membranes. J. Appl. Polym. Sci. 2010, 107, 1423–1429. [Google Scholar] [CrossRef]

| Levofloxacin Content (wt%) | 0 | 1 | 2 | 3 | 4 | 5 |
|---|---|---|---|---|---|---|
| (Dry state) Tensile strength (MPa) | 36.8 ± 3.32 | 35.2 ± 3.14 | 38.3 ± 2.71 | 43.4 ± 4.04 | 44.8 ± 1.34 | 45.4 ± 3.54 |
| (Wet state) Tensile strength (MPa) | 13.8 ± 0.87 | 16.7 ± 1.43 | 15.1 ± 1.16 | 18.4 ± 2.58 | 22.5 ± 3.74 | 18.2 ± 2.12 |
| (Dry state) Elongation at break (%) | 4.01 ± 0.12 | 5.25 ± 0.17 | 5.67 ± 0.14 | 6.47 ± 0.53 | 7.32 ± 0.47 | 9.82 ± 1.01 |
| (Wet state) Elongation at break (%) | 41.4 ± 4.12 | 41.1 ± 3.56 | 50.1 ± 5.03 | 54.5 ± 4.18 | 66.9 ± 6.47 | 67.3 ± 5.28 |
| Levofloxacin Content | 5 μg | 0 wt% | 1 wt% | 2 wt% | 3 wt% | 4 wt% | 5 wt% |
|---|---|---|---|---|---|---|---|
| Escherichia coli | 34 mm | 8 mm | 34 mm | 36 mm | 35 mm | 35 mm | 36 mm |
| S. aureus | 29 mm | 6 mm | 30 mm | 31 mm | 33 mm | 33 mm | 33 mm |
Publisher’s Note: MDPI stays neutral with regard to jurisdictional claims in published maps and institutional affiliations. |
© 2022 by the authors. Licensee MDPI, Basel, Switzerland. This article is an open access article distributed under the terms and conditions of the Creative Commons Attribution (CC BY) license (https://creativecommons.org/licenses/by/4.0/).
Share and Cite
Han, S.; Zhang, Z.; Chen, J.; Li, J.; Zhou, M.; He, Z.; He, Z.; Li, L. Preparation of Antibacterial Gelatin/Genipin Nanofibrous Membrane for Tympanic Membrane Repair. Molecules 2022, 27, 2906. https://doi.org/10.3390/molecules27092906
Han S, Zhang Z, Chen J, Li J, Zhou M, He Z, He Z, Li L. Preparation of Antibacterial Gelatin/Genipin Nanofibrous Membrane for Tympanic Membrane Repair. Molecules. 2022; 27(9):2906. https://doi.org/10.3390/molecules27092906
Chicago/Turabian StyleHan, Shuying, Zhaohua Zhang, Jia Chen, Jie Li, Mi Zhou, Zejian He, Zhen He, and Longfei Li. 2022. "Preparation of Antibacterial Gelatin/Genipin Nanofibrous Membrane for Tympanic Membrane Repair" Molecules 27, no. 9: 2906. https://doi.org/10.3390/molecules27092906
APA StyleHan, S., Zhang, Z., Chen, J., Li, J., Zhou, M., He, Z., He, Z., & Li, L. (2022). Preparation of Antibacterial Gelatin/Genipin Nanofibrous Membrane for Tympanic Membrane Repair. Molecules, 27(9), 2906. https://doi.org/10.3390/molecules27092906

